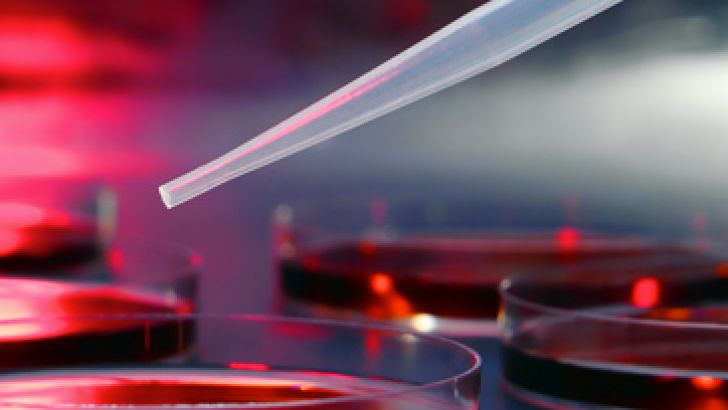

25 anni di Biotech a Padova. Primi passi, successi, visioni dal futuro

Come sarà il nostro futuro grazie alle biotecnologie?
Se ne parla mercoledì 26 giugno in occasione dei festeggiamenti dei 25 anni dal primo corso di laurea in Biotecnologie dell’Università di Padova, inaugurato nell’a.a. 1998/99 grazie a Mario Terzi, biologo molecolare del dipartimento di Biologia dell’Ateneo patavino.
Alla presenza del prorettore alla didattica Marco Ferrante, dei presidenti dei corsi di laurea in Biotecnologie, Livio Trainotti, e di laurea magistrale in Medical Biotechnologies, Sara Richter, in Pharmaceutical Biotechnologies, Stefano Salmaso, in Biotechnologies for Food Science, Fabio Vianello e in Biotecnologie industriali, Francesco Filippini, il convegno si articola in tre momenti: un excursus storico, alcune testimonianze e storie di successo e una tavola rotonda.
I protagonisti di allora ripercorreranno i passaggi cruciali di un momento - la fine degli anni Novanta - di grande entusiasmo e fermento per le biotecnologie, discipline trasversali per natura, che divennero oggetto di un corso di laurea interfacoltà nato con lo scopo di formare professionisti capaci di parlare un linguaggio multidisciplinare e di generare nuove applicazioni che nel tempo sono diventate fondamentali per le nostre vite.
Ex allieve e allievi, oggi ricercatrici e ricercatori, imprenditrici e imprenditori, porteranno poi la loro testimonianza raccontando storie e successi.
Ma si parla anche di futuro nel corso della tavola rotonda 'Visioni dal futuro' che precede la chiusura dell'incontro.
Modera Silvia Pittarello, esperta in comunicazione delle scienze.
Per partecipare è necessaria l'iscrizione.
- QUANDO 26 GIUGNO - ORE 14:00
-
Aula magna Azzone - Polo Antonio Vallisneri
Via Ugo Bassi, 58b - Padova
- PER MAGGIORI INFORMAZIONI Sito web